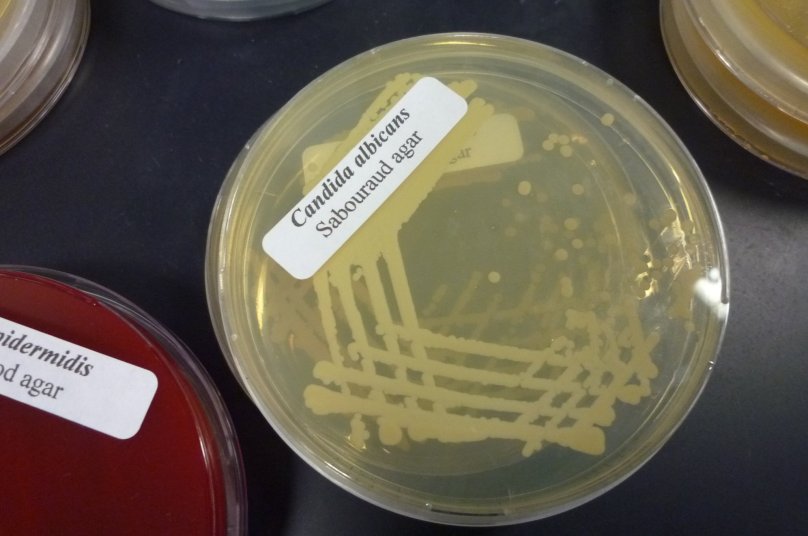
Культуральный метод исследования в микробиологии кандида

Ara cándido de lasala q 43
 Таблетки от кандидоза полости рта
Таблетки от кандидоза полости рта
 Строение кожного анализатора анатомия
Строение кожного анализатора анатомия
 Кандидоз слизистой оболочки полости рта
Кандидоз слизистой оболочки полости рта
 Cerere косметика
Cerere косметика
 Q: загадка женщины фильм 2011
Q: загадка женщины фильм 2011
 Псевдомицелий кандида
Псевдомицелий кандида
 Краска Тиккурила h484
Краска Тиккурила h484
 Обложки глав Ван Пис 1 глава
Обложки глав Ван Пис 1 глава
 Домашний тест на кандиду со стаканом
Домашний тест на кандиду со стаканом
 Кандид б6 таблетки Вагинальные
Кандид б6 таблетки Вагинальные
 Европейские женщины
Европейские женщины
 0 204 104 308
0 204 104 308
 Кандида микроскопия
Кандида микроскопия
Культуральный метод исследования в микробиологии кандида
Культуральный метод исследования в микробиологии кандида
 Кандида альбиканс микроскоп
Кандида альбиканс микроскоп
 Лириана аниме
Лириана аниме
 (2/5-6,6) :(1 1/4- 11/3) Решение
(2/5-6,6) :(1 1/4- 11/3) Решение
 Джуэл Стэйт Светлячок
Джуэл Стэйт Светлячок
Похожие фотографии